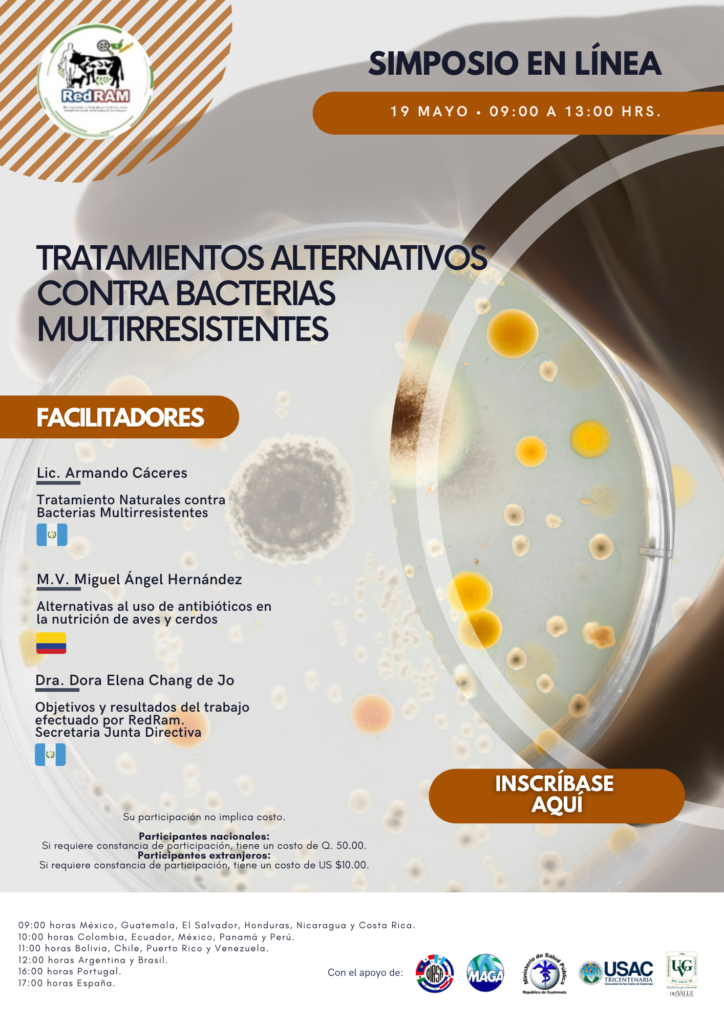

781 total views, 5 views today
- Actualización Profesional
Invitación – Simposio en línea: Tratamientos alternativos contra bacterias multirresistentes.
Invitación – Simposio en línea: Tratamientos alternativos contra bacterias multirresistentes.
No.
788A
Profesión
Química Farmacéutica
Fecha de Actividad
19 de mayo de 2023 de 9:00 a 13:00 horas
Link
781 total views

